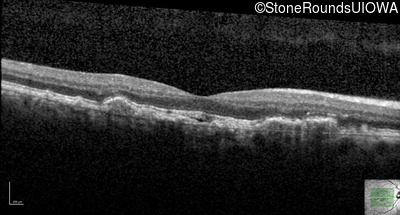
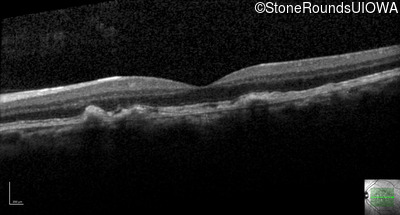
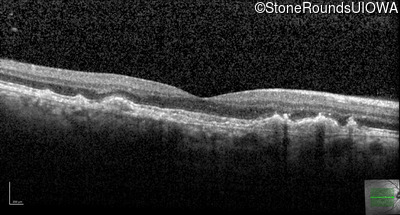
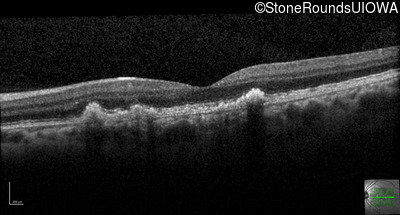

Case
SR2308
Student Mode
Malattia Leventinese (IIJ)
Male
Male
Hidden
SR2308
Student Mode
Malattia Leventinese (IIJ)
Male
Male
Highlighted Images
| Age at visit: 32 years | OD | OS |
|---|---|
History
This 32 year old man has a chief complaint of mildly reduced visual acuity. He first noticed a slow recovery of acuity after exposure to bright light at age 18. His visual acuity was completely normal as a child and young adult.
Teaching Points
The clinical features favoring the diagnosis of Malattia Leventinese in this patient include the confluent drusen (some with dark cores), the relatively good visual acuity, the radial drusen temporal and inferior to the macula, and the extensive autosomal dominant family history. Autosomal dominant macular dystrophies often have good acuity despite a fairly dramatic fundus appearance.
| Age at visit: 32 years |
| OD | OS | ||
|---|---|---|---|
| OD | OS | ||
|---|---|---|---|
| Age at visit: 34 years |
| OD | OS | ||
|---|---|---|---|
Diagnosis & molecular findings
| Disease | Gene | Allele 1 variant(s) | Allele 2 variant(s) | Inheritance mode |
|---|---|---|---|---|
| Malattia Leventinese | EFEMP1 | Arg345Trp CGG>TGG | AD |